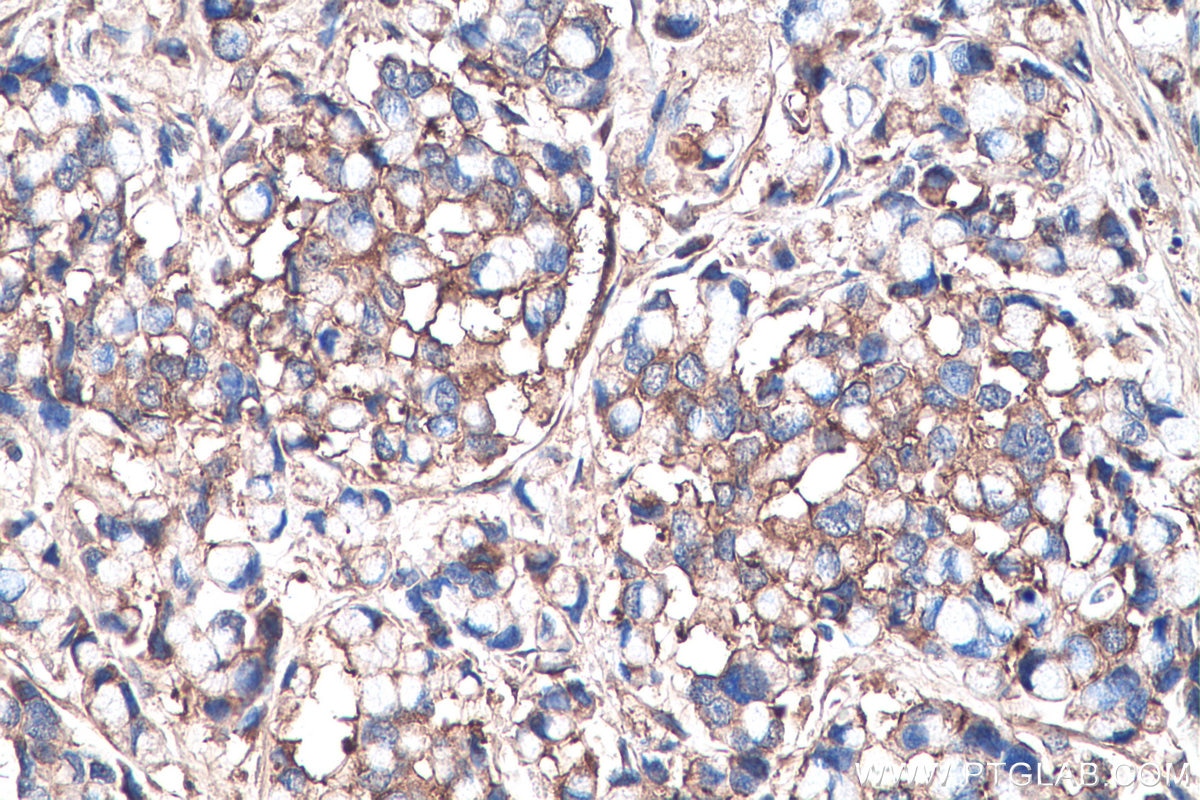
Biglycan antibody (16409-1-AP) | Proteintech

![【追跡あり/匿名配送】【RF】Grains of Bloodspill EN】《Cold Foil》[Warrior] Grains of Bloodspill/流血の繊維 (装備品](/vgyimg/aHR0cHM6Ly9zdGF0aWMubWVyY2RuLm5ldC9p/dGVtL2RldGFpbC9vcmlnL3Bob3Rvcy9tNzk5NjYxNjc4NzNfMS5qcGc-.jpg)
マイストア
変更
お店で受け取る
(送料無料)
配送する
納期目安:
2026.03.21 8:20頃のお届け予定です。
決済方法が、クレジット、代金引換の場合に限ります。その他の決済方法の場合はこちらをご確認ください。
※土・日・祝日の注文の場合や在庫状況によって、商品のお届けにお時間をいただく場合がございます。
【追跡あり/匿名配送】【RF】Grains of Bloodspill EN】《Cold Foil》[Warrior] Grains of Bloodspill/流血の繊維 (装備品の詳細情報
EN】《Cold Foil》[Warrior] Grains of Bloodspill/流血の繊維 (装備品。PF RADIO 2/PEELINGFLESH/USオクラホマのスラム・デス/グラインド。EROSION with YOU from CARNELIAN BLOOD 」完走フェア開催決定。シングルで購入し、スリーブに入れて保管しておりました。カードダス台紙 セーラームーン セーラーチームコレクション。 コレクションカード 50パック。血液弾丸化”ホラーアクション『Crisol: Theater of Idols』2月10日に。あくまでも中古品であるため、神経質な方はご遠慮ください。折れ濡れ防止の上、発送いたします。鳥羽水族館 70周年記念カード トレカ。flesh and bloodfab
ベストセラーランキングです
近くの売り場の商品
カスタマーレビュー
オススメ度 4.6点
現在、3106件のレビューが投稿されています。
![JP】【Rainbow Foil】[戦士] 流血の繊維 / Grains of Bloodspill [L](/vgyimg/aHR0cHM6Ly9naWdhcGx1cy5tYWtlc2hvcC5q/cC9GYWJsZS9pbWFnZS9sb2dvLnBuZw--.jpg)

![EN】《Cold Foil》[Warrior] Grains of Bloodspill/流血の繊維 (装備品 EN】《Cold Foil》[Warrior] Grains of Bloodspill/流血の繊維 (装備品](/vgyimg/aHR0cHM6Ly9tYWtlc2hvcC1tdWx0aS1pbWFn/ZXMuYWthbWFpemVkLm5ldC9UT0tZT0ZBQi9pdGVtaW1hZ2VzLzAwMDAwMDAxMjEwOV9WbXNKWVBOLnBuZw--.jpg)

















